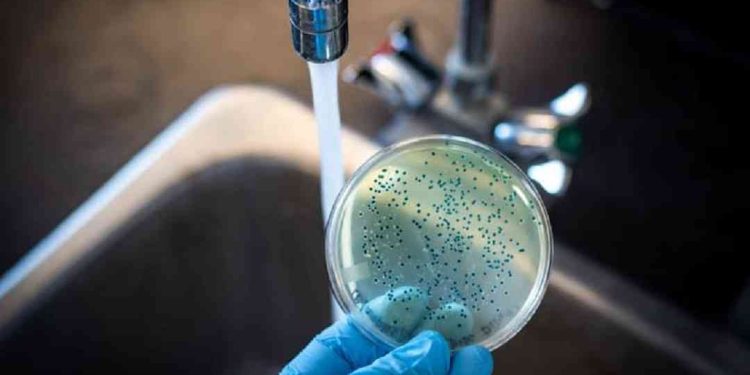
Vi sinh vật trong nước uống thường gây hại

Vi sinh vật trong nước là các loại sinh vật sống, và các tác động đến con người. Khác với suy nghĩ của nhiều người, vi sinh vật không chỉ có tác động tiêu cực mà còn có giá trị tích cực. Trong xử lý nước thải, chúng đóng vai trò lớn trong việc phân giải và làm sạch nước thải nhanh hơn, hiệu quả hơn.

Vi sinh vật trong nước là gì?
Vi sinh vật là những sinh vật có kích thước rất nhỏ, mắt thường không thể nhìn thấy. Chúng tồn tại ở nhiều môi trường khác nhau như đất, nước, không khí, trên cơ thể các loại động, thực vật khác,… Tuy rằng có kích thước rất nhỏ, nhưng chúng lại có sức sống vô cùng mãnh liệt, mạnh mẽ hơn bất cứ sinh vật nào chúng ta nhìn thấy được.
Về mặt khoa học, vi sinh vật trong nước cũng được xem như một cơ thể sống, có cấu trúc tế bào. Chúng có thể là sinh vật nhân sơ hoặc nhân thực.

Đặc điểm của vi sinh vật
- Không nhìn thấy bằng mắt, kích thước thường được đo bằng micromet. Phải cần đến kính hiển vi mới có thể nhìn rõ được cấu tạo bên trong.
- Tồn tại tốt ở những điều kiện môi trường khắc nghiệt: nước nhiệt độ rất cao, rất thấp (đóng băng), nước mặn…
Chúng ta thường dùng dung dịch muối để sát khuẩn, sát trùng. Cứ tưởng rằng, nước mặn là môi trường mà vi sinh khó thể tồn tại. Rất nhiều loại vi sinh vật trong nước thải cũng bị chết bởi nồng độ muối cao, độ pH thấp, dinh dưỡng thấp hơn nước ngọt. Nhưng sự thật không phải như vậy, vẫn có các loài sống được trong nguồn nước mặn.
Chọn lọc tự nhiên cho phép nhiều loại vi khuẩn ưa mặn sinh sôi, phong phú không kém trong môi trường nước ngọt. Phổ biến nhất là hiện tượng thủy triều đỏ. Chúng là kết quả của sự phát triển và nhân lên nhanh chóng của tảo, khiến nước chuyển sang màu đỏ, cạn kiệt lượng oxy, dinh dưỡng, khiến nhiều loài cá chết.
Các loại vi sinh vật trong xử lý nước thải
Vi sinh vật bao gồm nhiều loài: vi khuẩn, động vật nguyên sinh, tảo và nấm. Tất cả các loại này đều có thể tồn tại trong nước. Hơn nữa, nước còn là một phương tiện lý tưởng để phát tán vi sinh vật đến nhiều nơi hơn, mở rộng phạm vi xuất hiện nhanh chóng hơn bất kì sinh vật khác.
Vi khuẩn
Vi khuẩn là một trong những quần thể vi sinh vật lớn nhất. Về mặt cấu tạo sinh học, chúng là một sinh vật nhân sơ (không có nhân trong tế bào và không chứa các bào quan). Số lượng vi khuẩn trong tự nhiên rất lớn. Chúng phát triển mạnh mẽ trong nhiều môi trường (đất, nước, không khí) và cả trên cơ thể con người.
Khác với lầm tưởng của nhiều người rằng: vi khuẩn luôn đem lại tác hại. Không những vẫn có những loài vô hại trong cơ thể người, mà chúng còn hỗ trợ cho hoạt động sống của chúng ta.
Để tiêu hóa tốt, trong hệ đường ruột cần có sự tham gia của nhiều lợi khuẩn: Lactobacilli, Bifidobacteria, Bacillus clausii,… Hệ vi khuẩn có tác dụng bảo vệ đường ruột, tăng cường miễn dịch, giảm các bệnh lý dị ứng.
Tuy nhiên, bên cạnh đó, cũng có nhiều nhiều vi khuẩn gây hại cho con người. So sánh tương quan giữa số loài vi khuẩn gây hại và có lợi, số lượng vi khuẩn có hại ít hơn rất nhiều.

Nấm
Nấm là loại vi sinh vật khá quen thuộc với chúng ta. Nếu bạn đã từng nhìn thấy những vệt đen lốm đốm trên mẩu bánh mì bị ẩm, để lâu ngày thì đó chính là nấm. Khi phát triển đến một mức độ nhất định, chúng ta có thể nhìn thấy chúng bằng mắt thường. Còn với số cá thể nhỏ, bạn vẫn cần đến kính hiển vi mới có thể soi rõ.
So với vi khuẩn, nấm đã ở mức tiến hóa cao hơn, là sinh vật nhân thực (tế báo có nhân và các bào quan). Chúng cũng có khả năng tác động đến sức khỏe con người rất lớn, đặc biệt với những người có hệ miễn dịch kém. Sử dụng nước hay bất kì thực phẩm nào chứa nấm mốc là nguyên nhân dẫn đến đau đầu, buồn nôn, mệt mỏi, dị ứng,…
Ở một góc độ khác, nấm vẫn mang đến nhiều yếu tố tích cực trong cuộc sống. Trong ngành công nghiệp thực phẩm, nấm lên men là trong những nguyên liệu đầu vào quan trọng để sản xuất bia, rượu, nước tương, pho – mát, bánh mì,…
Virus
Ngày nay, có nhiều tranh cãi xung quanh virus có phải là vi sinh vật không. Virus là dạng tiến hóa trung gian giữa cơ thể sống và không sống. Chúng không có khả năng tự sinh sản nếu không có vật chủ và không có phản ứng thay đổi khi điều kiện môi trường biến đổi.
Virus xâm nhập vào cơ thể, thực hiện xâm lấn vào hoạt động của tế bào sống. Khi đó, phản ứng tự vệ bản năng của cơ thể thực hiện tiêu diệt chúng và gây nên các triệu chứng như ho, cảm lạnh, cúm,…
Con người đã từng chứng kiến nhiều đại dịch nguy hiểm, nguyên nhân do virus là nỗi khiếp sợ của loài người. Virus Ebola, bệnh dại, đậu mùa, Sar – CoV-2,… là những ví dụ điển hình về sức mạnh của virus.
Tảo
Nhiều người lầm tưởng rằng những đám tảo xanh trên mặt nước là thực vật, bởi chúng còn có khả năng quang hợp. Thế nhưng, thực chất chúng là vi sinh vật, bao gồm cả nhân sơ và nhân thực.
Tảo thường được tìm thấy trong môi trường nước, có khả năng phát triển, mở rộng nhanh chóng bao phủ cả mặt nước. Ao tù, nước đọng, nước ô nhiễm là điều kiện thích hợp cho tảo phát triển. Sự chiếm lĩnh của loài tảo là nguyên nhân khiến các loài động vật trong nước bị chết và suy giảm do thiế oxy trầm trọng.

Động vật nguyên sinh
Động vật nguyên sinh là những sinh vật đơn bào, nhưng chúng có thể có đầy đủ hoạt động trao đổi chất như cơ thể đa bào. Bạn có thể không biết rằng, trên khắp trái đất có đến 26000 loài. Trong đó, có cả những loài sống ở nơi băng giá nhất hành tinh (Nam Cực), đồng thời có cả những loài sống ở nơi nóng gay gắt nhất (sa mạc Sahara).
Trong đó, nổi bật nhất phải kể đến Giardia và Cryptosporidium – thường sống trong đường ruột của một số loài động vật như hươu. Hóa chất diệt khuẩn Clo cũng không thể tiêu diệt loại vi sinh vật này, đủ cho bạn thấy sức mạnh của loại vi sinh vật này.
Vi sinh vật trong nước uống
Vi sinh vật trong nước uống thường gây hại
Nước là môi trường lý tưởng cho các loại vi sinh vật trong nước uống sinh sống và phát triển. Tuy nhiên, chúng có thể khác nhau về thành phần, chủng loại.
Sự hiện diện của vi sinh vật trong nước uống không đem lại lợi ích cho sức khỏe, thậm chí chúng có thể gây nguy hiểm tới tính mạng. Trong thế giới sinh vật, số loài vi sinh vật nhỏ bé, nhưng có thể có số lượng loài nhiều hơn rất nhiều so với động và thực vật. Đặc biệt bởi khả năng tiến triển, nhân lên và tiến hóa nhanh.
Virus Covid – 19 tuy không có nguồn gốc bắt nguồn từ nước, nhưng chúng là một ví dụ điển hình cho sự nhân lên và tiến hóa mạnh mẽ. Chỉ trong vòng một năm, virus đã biến đổi thành trên 3 biến thể, khiến con người quay cuồng tìm phương hướng giải quyết.

Các cách hạn chế vi sinh vật trong nước uống
Để đảm bảo an toàn cho con người, nước uống thường được xử lý bằng nhiều cách để giảm nguy cơ gây hại của các loài này. Đun sôi nước là một giải pháp truyền thống, đã được dân gian áp dụng từ xưa đến nay.
Bạn có thể nhận biết trực quan chất lượng nước thông qua độ đục. Nước càng đục thì mật độ vi sinh vật càng lớn. Tuy nhiên, đó cũng chỉ là giải pháp trước mắt, bởi nước uống trong vẫn chứa rất nhiều loài mà chúng ta không nhìn thấy.
Đồng thời, đây cũng là bài toán cho ngành khoa học liên tục đi tìm lời giải, giải pháp tiên tiến hơn. Ngày nay, có rất nhiều giải pháp đã được đề xuất và thực hiện thành công trong đời sống. Sử dụng Clo, Ozone, đèn UV là các cách có thể tiêu diệt vi sinh vật hiệu quả trên 99%.

Để đáp ứng nhu cầu tiêu dùng hàng ngày, ứng dụng thành quả nghiên cứu vào đời sống, máy lọc nước diệt khuẩn ra đời. Đặc biệt công nghệ sử dụng trong các máy lọc nước sinh hoạt này không sử dụng đến hóa chất, đảm bảo an toàn tuyệt đối cho người dùng. Việc tiếp cận đến nguồn nước diệt khuẩn, virus giờ đây không còn khó khăn như bạn nghĩ.
Vi sinh vật vẫn luôn tồn tại trong nguồn nước, bao gồm cả nước uống và nước thải. Tuy nhiên, không phải lúc nào vi sinh vật cũng gây hại, trong một số trường hợp chúng hỗ trợ cho công việc của chúng ta.
Nhờ có sự tham gia của vi sinh vật trong xử lý nước thải, quá trình làm sạch các tạp chất diễn ra thuận lợi hơn bao giờ hết. Đến nay phương pháp xử lý nước thải sinh học vẫn là phương pháp tốt nhất để xử lý nước thải hữu cơ.

Để xây dựng kiến thức học đường trong môi trường hiện nay cần phải có sự tác động nhiều chiều, từ nhiều chủ thể khác nhau.
Cùng theo dõi giaoduchocduong24h.net để có những thông tin đáng đọc nhé.
